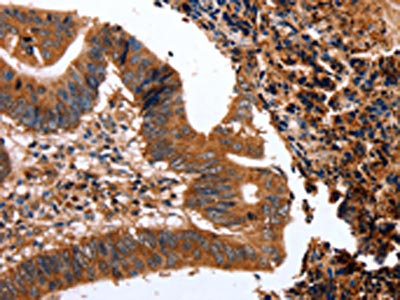

CLEC4A Antibody
-
中文名稱:CLEC4A兔多克隆抗體
-
貨號(hào):CSB-PA016840
-
規(guī)格:¥1100
-
圖片:
-
The image on the left is immunohistochemistry of paraffin-embedded Human colon cancer tissue using CSB-PA016840(CLEC4A Antibody) at dilution 1/15, on the right is treated with fusion protein. (Original magnification: ×200)
-
The image on the left is immunohistochemistry of paraffin-embedded Human lung cancer tissue using CSB-PA016840(CLEC4A Antibody) at dilution 1/15, on the right is treated with fusion protein. (Original magnification: ×200)
-
Gel: 12+15%SDS-PAGE, Lysate: 40 μg, Lane 1-4: RAW264.7, Hela cells, 823 cells, A549 cells, Primary antibody: CSB-PA016840(CLEC4A Antibody) at dilution 1/300, Secondary antibody: Goat anti rabbit IgG at 1/8000 dilution, Exposure time: 10 minutes
-
-
其他:
產(chǎn)品詳情
-
Uniprot No.:
-
基因名:
-
別名:C type (calcium dependent carbohydrate recognition domain) lectin superfamily member 6 antibody; C type lectin antibody; C type lectin DDB27 antibody; C type lectin superfamily 6 antibody; C-type (calcium dependent; carbohydrate-recognition domain) lectin; superfamily member 6 antibody; C-type lectin superfamily member 6 antibody; C-type lectin DDB27 antibody; C-type lectin domain family 4 member A antibody; C-type lectin domain family 4; member A antibody; C-type lectin domain family 4; member a2 antibody; C-type lectin superfamily member 6 antibody; CLC4A_HUMAN antibody; Clec4a antibody; Clec4a2 antibody; CLECSF6 antibody; DCIR antibody; Dcir1 antibody; DDB27 antibody; Dendritic cell immunoreceptor antibody; HDCGC13P antibody; Lectin like immunoreceptor antibody; Lectin; C-type; superfamily member 6 antibody; Lectin-like immunoreceptor antibody; LLIR antibody
-
宿主:Rabbit
-
反應(yīng)種屬:Human,Mouse
-
免疫原:Fusion protein of Human CLEC4A
-
免疫原種屬:Homo sapiens (Human)
-
標(biāo)記方式:Non-conjugated
-
抗體亞型:IgG
-
純化方式:Antigen affinity purification
-
濃度:It differs from different batches. Please contact us to confirm it.
-
保存緩沖液:-20°C, pH7.4 PBS, 0.05% NaN3, 40% Glycerol
-
產(chǎn)品提供形式:Liquid
-
應(yīng)用范圍:ELISA,WB,IHC
-
推薦稀釋比:
Application Recommended Dilution ELISA 1:1000-1:5000 WB 1:200-1:1000 IHC 1:50-1:200 -
Protocols:
-
儲(chǔ)存條件:Upon receipt, store at -20°C or -80°C. Avoid repeated freeze.
-
貨期:Basically, we can dispatch the products out in 1-3 working days after receiving your orders. Delivery time maybe differs from different purchasing way or location, please kindly consult your local distributors for specific delivery time.
-
用途:For Research Use Only. Not for use in diagnostic or therapeutic procedures.
相關(guān)產(chǎn)品
靶點(diǎn)詳情
-
功能:C-type lectin receptor that binds carbohydrates mannose and fucose but also weakly interacts with N-acetylglucosamine (GlcNAc) in a Ca(2+)-dependent manner. Involved in regulating immune reactivity. Once triggered by antigen, it is internalized by clathrin-dependent endocytosis and delivers its antigenic cargo into the antigen presentation pathway resulting in cross-priming of CD8(+) T cells. This cross-presentation and cross-priming are enhanced by TLR7 and TLR8 agonists with increased expansion of the CD8(+) T cells, high production of IFNG and TNF with reduced levels of IL4, IL5 and IL13. In plasmacytoid dendritic cells, inhibits TLR9-mediated IFNA and TNF production. May be involved via its ITIM motif (immunoreceptor tyrosine-based inhibitory motifs) in the inhibition of B-cell-receptor-mediated calcium mobilization and protein tyrosine phosphorylation.; (Microbial infection) Involved in the interaction between HIV-1 virus and dendritic cells. Enhances HIV-1 binding/entry and virus infection. Requires ITIM motif-associated signal transduction pathway involving phosphatases PTPN6 and PTPN11, SYK, Src kinases and MAP kinases.
-
基因功能參考文獻(xiàn):
- Authors have determined the structure, tissue distribution, and molecular function of the cartilage-specific lectin CLEC3A and show that CLEC3A binds to plasminogen and participates in tPA-mediated plasminogen activation. PMID: 29146595
- DCIR SNP rs2377422 is a novel genetic susceptibility factor for both SLE and primary SS. PMID: 26429306
- this study shows that sulfo-Lewis(a) is a high affinity ligand for DCIR and that DCIR interacts with ligands from both pathogenic and endogenous origin of which most are shared by DC-SIGN. PMID: 24239607
- No association was found between our inflammatory bowel disease cohort and the candidate single nucleotide polymorphisms for DCIR (CD/HC: P=0.22 and UC/HC: P=0.41) PMID: 22664939
- Data provide evidence for association between DCIR rs2377422 and RA in non-Caucasian populations and confirm the influence of DCIR polymorphisms on RA susceptibility, especially on ACPA-negative RA. PMID: 22829930
- An involvement of ITIM domain in HIV-1-mediated signaling events and a relationship between phosphorylation events and DCIR function with respect to HIV-1 biology. PMID: 21536857
- Data show that antigen targeting via the DCIR receptor allows activation of specific CD8(+) T-cell immunity. PMID: 20530286
- CLECSF6 is involved in the control of inflammation in neutrophils PMID: 14550269
- The phosphorylation of SHP-2 by GM-CSF promotes the binding of SHP-2 to the GM-CSF receptor to the disadvantage of CLECSF6. PMID: 16360206
- Human APLEC and DCIR may be associated with susceptibility to anti-CCP-negative rheumatoid arthritis. PMID: 17665455
- The data show that targeting of DCIR can modulate human plasmacytoid dendritic cell function and may be applied in disease prevention and treatment. PMID: 18258799
- The mRNA expression from the four known transcripts of DCIR in IFN-gamma-treated human leukocytes together with fine mapping across the locus was analyzed. PMID: 18480830
- can participate in the capture of HIV-1 and promote infection in trans and in cis of autologous CD4(+) T cells from human immature monocyte-derived DCs. PMID: 18541725
- DCIR as an antigen presenting cell receptor that is endocytosed efficiently in a clathrin-dependent manner and negatively affects TLR8-mediated cytokine production. PMID: 19028959
顯示更多
收起更多
-
亞細(xì)胞定位:Cell membrane; Single-pass type II membrane protein; Extracellular side.
-
組織特異性:Expressed preferentially in hematopoietic tissues. Expressed in all circulating Ag-presenting cells such as dendritic cells, myeloid cells, monocytes, macrophages, B-cells and epidermal Langerhans cells (at protein level). Expressed in peripheral blood le
-
數(shù)據(jù)庫鏈接:
Most popular with customers
-
-
YWHAB Recombinant Monoclonal Antibody
Applications: ELISA, WB, IHC, IF, FC
Species Reactivity: Human, Mouse, Rat
-
Phospho-YAP1 (S127) Recombinant Monoclonal Antibody
Applications: ELISA, WB, IHC
Species Reactivity: Human
-
-
-
-
-
VDAC1 Recombinant Monoclonal Antibody
Applications: ELISA, WB, IHC
Species Reactivity: Human, Mouse, Rat